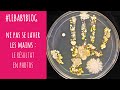

| |
|
 | | time | views | |
 | 6 MOIS POUR MINCIR - Yoga & Fitness 3ème mois | 0:52 | 1,490 | |
 | Rééquilibrage alimentaire : quelle quantité de sucre dans la journée ? | 1:90 | 2,947 | |
 | 6 MOIS POUR MINCIR – 5eme Coaching Nutrition J+ 2 mois | 0:54 | 1,805 | |
 | Zumba & Perte de poids – 3ème mois | 0:49 | 4,078 | |
 | Rééquilibrage alimentaire : bien lire les étiquettes | 1:20 | 3,127 | |
 | 6 MOIS POUR MINCIR – Coaching sportif 3eme mois | 1:20 | 1,957 | |
 | L’actualité de la semaine en 30 secondes ! (17-07-2015) | 0:28 | 1,622 | |
 | Sophrologie et perte de poids | 0:90 | 2,036 | |
 | 6 MOIS POUR MINCIR – 3eme Coaching Nutrition J+45 jours | 0:45 | 2,094 | |
 | Que peut-on manger avant et/ou après le sport ? | 0:47 | 7,378 | |
 | 6 MOIS POUR MINCIR – Renforcement musculaire 2ème mois | 0:12 | 2,453 | |
 | 6 MOIS POUR MINCIR – Stretching 2ème mois | 0:13 | 1,641 | |
 | 6 MOIS POUR MINCIR – Cardio-training 2ème mois | 0:13 | 2,124 | |
 | L’actualité de la semaine en 30 secondes (10-07-2015) | 0:38 | 1,699 | |
 | Hypnose et perte de poids | 0:19 | 2,145 | |
 | Les cures de jus sont-elles intéressantes pour perdre du poids ? | 1:23 | 3,278 | |
 | L'actu de la semaine en 30 secondes ! (03/07/2015) | 0:27 | 4,132 | |
 | 6 MOIS POUR MINCIR – Coaching sportif 2eme mois | 0:15 | 2,171 | |
 | 6 MOIS POUR MINCIR –Coaching Nutrition J+30 jours | 0:52 | 1,969 | |
 | Auto massage Visage | 6:30 | 3,017 | |
 | Comment faire des Swings ? | 3:54 | 2,258 | |
 | L'actualité de la semaine en 30 secondes ! (26/06/2015) | 0:32 | 3,595 | |
 | Sophrologie pour éviter le Burn-out | 14:70 | 2,150 | |
 | Comment rattraper un écart alimentaire ? | 1:26 | 4,161 | |
 | Auto-massage Contour des yeux | 2:22 | 2,955 | |
 | Méditation et perte de poids | 0:11 | 2,828 | |
 | L’actualité de la semaine en 30 secondes ! (19/06/2015) | 0:29 | 1,457 | |
 | Auto-massage Ventre plat | 5:23 | 7,745 | |
 | 6 MOIS POUR MINCIR – 2eme Coaching Nutrition J+15 | 0:58 | 2,135 | |
| L’actualité de la semaine en 30 secondes ! (12/06/2015) | 0:34 | 2,583 | |
 | Que faire en cas de lumbago ? | 1:50 | 2,015 | |
 | 6 MOIS POUR MINCIR – Stretching 1er mois | 0:14 | 5,133 | |
 | Que faire en cas de torticolis ? | 1:23 | 2,076 | |
 | L'actualité de la semaine en 30 secondes (05/06/2015) | 0:32 | 2,223 | |
 | 6 MOIS POUR MINCIR – Renforcement Musculaire 1er mois | 0:13 | 3,842 | |
 | Auto-massage palper-rouler | 2:30 | 5,319 | |
 | 6 MOIS POUR MINCIR – Cardio-training 1er mois | 0:14 | 4,058 | |
 | Comment soigner une entorse ? | 2:80 | 2,124 | |
 | 6 MOIS POUR MINCIR – 1er rdv rééquilibrage alimentaire | 0:11 | 3,935 | |
 | 6 MOIS POUR MINCIR – 1er coaching sportif | 0:29 | 3,853 | |
 | L'actualité de la semaine en 30 sec ! (29/05/2015) | 0:32 | 1,495 | |
 | Comment entretenir sa barbe ? | 1:56 | 3,722 | |
 | Tailler Comment tailler sa barbe ? | 3:36 | 8,620 | |
 | Petit déjeuner minceur | 1:29 | 5,756 | |
 | Les bases d’un rééquilibrage alimentaire | 1:41 | 7,157 | |
 | Les chaussettes de compression pour le running : à quoi ça sert ? | 1:28 | 2,513 | |
 | L'actualité de la semaine en 30 secondes (22/05/2015) | 0:28 | 2,429 | |
 | Teaser 6 Mois Pour Mincir | 1:17 | 9,690 | |
 | Quelle tenue pour courir ? | 1:47 | 3,995 | |
 | Bien appliquer sa poudre de soleil | 2:57 | 2,259 | |
 | Déchirure musculaire : comment la soigner ? | 5:45 | 2,555 | |
 | Yoga pour le dos | 14:80 | 3,166 | |
 | L'actualité de la semaine en 30 sec - 8 mai 2015 | 0:32 | 2,582 | |
 | Fitness Après Grossesse – Semaine 8 | 14:26 | 2,378 | |
 | Contracture musculaire : comment la soigner ? | 2:50 | 2,554 | |
 | Sophrologie pour arrêter de fumer | 8:41 | 2,106 | |
 | Quand le Bodysculptor s’attaque à la cellulite | 3:30 | 1,927 | |
 | Fitness Après Grossesse – Semaine 7 | 19:18 | 1,839 | |
 | Comment choisir ses chaussures de running ? | 1:59 | 3,034 | |
 | Sophrologie et migraine | 9:48 | 2,227 | |
 | L'actualité de la semaine en 30 sec - 24 Avril 2015 | 0:32 | 1,475 | |
 | Prévenir et soigner les caries dentaires | 4:00 | 1,855 | |
 | Bien appliquer sa poudre libre | 2:52 | 1,809 | |
 | Fitness Après Grossesse – Semaine 6 | 12:31 | 2,206 | |
 | Que faut-il manger le soir pour bien dormir ? | 1:31 | 4,188 | |
 | Les vertus d’un sommeil de qualité | 1:49 | 2,221 | |
 | L'actualité de la semaine en 30 sec - 17 Avril 2015 | 0:30 | 1,771 | |
 | Infertilité : quand la PMA ne marche pas… | 2:10 | 485 | |
 | Comment appliquer son anti-cernes ? | 3:53 | 1,797 | |
 | Yoga Dynamique Vinyasa | 13:33 | 1,167 | |
 | Bien dormir pour garder la ligne | 2:51 | 2,841 | |
 | Yoga : Posture du Poisson - Matsyasana | 6:11 | 1,029 | |
 | Massage japonais | 1:49 | 1,474 | |
 | L’actu de la semaine en 30 secondes - 10 Avril 2015 | 0:29 | 804 | |
 | Que penser de l’autotest de fertilité masculine disponible en pharmacie ? | 1:48 | 610 | |
 | Comment démaquiller ses ongles ? | 2:40 | 1,291 | |
 | Test du Disq Sculpt | 4:38 | 2,124 | |
 | Qu’est-ce que l’autisme ? | 1:19 | 1,176 | |
 | Les patients autistes sont-ils plus souvent victimes d’autres troubles ? | 1:25 | 310 | |
 | Quelles sont les voies de recherche face à l’autisme ? | 1:30 | 187 | |
 | Autisme : quelles sont les aides administratives et économiques pour les familles ? | 2:14 | 301 | |
 | Les méthodes psycho-éducatives face à l’autisme | 3:11 | 318 | |
 | Autisme : comment s’établit le diagnostic ? | 0:50 | 366 | |
 | Autisme : qui consulter en cas de suspicion ? | 1:24 | 202 | |
 | Quels sont les causes de l’autisme ? | 1:21 | 451 | |
 | L’autisme est-il une maladie génétique ? | 1:21 | 394 | |
 | Autisme : comment favoriser l’intégration dans le monde du travail ? | 0:51 | 172 | |
 | Qu’est-ce que le syndrome d’Asperger ? | 2:29 | 636 | |
 | La psychanalyse a-t-elle encore une place dans la prise en charge de l’autisme ? | 1:39 | 184 | |
 | L’autisme peut-il être guéri ? | 1:21 | 214 | |
 | Autisme : les familles sont des partenaires de la prise en charge | 5:18 | 149 | |
 | Quels sont les traitements de l’autisme ? | 4:44 | 203 | |
 | Autisme : à partir de quel âge peuvent apparaître les symptômes ? | 1:59 | 59 | |
 | Quels sont les symptômes de l’autisme ? | 2:57 | 439 | |
 | Courbatures : comment les soulager ? | 2:35 | 2,070 | |
 | Comment bien poser son vernis à ongles ? | 2:59 | 3,323 | |
 | Les News de la Semaine - 3 Avril 2015 | 0:52 | 1,371 | |
 | Difficultés à tomber enceinte : quand s’inquiéter ? | 1:40 | 1,268 | |
 | Comment limer ses ongles sans les abîmer ? | 3:14 | 1,405 | |
 | Crampes : comment les soulager ? | 1:46 | 1,713 | |
|
|
|